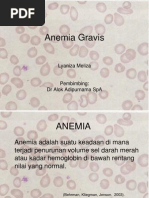

100%(1)100% menganggap dokumen ini bermanfaat (1 suara)
714 tayangan3 halamanAsites PAPDI
penangan asites pada hipertensi portal
Diunggah oleh
shintapediaHak Cipta
© © All Rights Reserved
Kami menangani hak cipta konten dengan serius. Jika Anda merasa konten ini milik Anda, ajukan klaim di sini.
Format Tersedia
Unduh sebagai PDF atau baca online di Scribd
100%(1)100% menganggap dokumen ini bermanfaat (1 suara)
714 tayangan3 halamanAsites PAPDI
penangan asites pada hipertensi portal
Diunggah oleh
shintapediaHak Cipta
© © All Rights Reserved
Kami menangani hak cipta konten dengan serius. Jika Anda merasa konten ini milik Anda, ajukan klaim di sini.
Format Tersedia
Unduh sebagai PDF atau baca online di Scribd
256
ASITES
Hirlan
PENDAHULUAN
Asites adalah penimbunan cairan secara abnormal di
rongga peritoneum, Asites dapat disebabkan oleh banyak
penyakit. Pada dasarnya penimbunan cairan di rongga
peritoneum dapat terjaci melalui 2 mekanisme dasar yakni
transudasi dan eksudasi. Asites yang ada hubungannya
dengan sirosis hati dan hipertensi porta adalah salah satu.
contoh penimbunan cairan di rongga peritoneum yang,
terjadi melalui mekanisme transudasi. Asitesjenis ni paling
sering dijumpai di indonesia. Asites merupakan tanda
prognosis yang kurang balk pada beberapa penyakit.
Asites juga menyebabskan pengelolaan penyakit dasamya
menjadi semakin kompleks. infeksi pada cairan asites akan
lebih memperberat perjalanan penyakit dasarnya oleh
karena itu asites harus dikelola dengan baik. Pada bagian,
ini terutama akan dibahas lebih dalam asites akibat sirosis,
hati dan hipertenci porta
PATOFISIOLOGI
‘Ada beberapa teori yang menerangkan patofisiologi
asites transudasi, Teori- teori itu misalnya underfilling,
overfilling dan periferal vasodilatation. Menurut teori
Underfilling asites dimulai dari volume cairan plasma yang
menurun akibat hipertensi porta dan hipoalbuminemia,
Hipertensi porta akan meningkatkan tekanan hidrostatik
venosa ditambah hipoalbuminemia akan menyebabkan,
transudasi, sehingga volume cairan intravaskular menurun.
‘Akibat volume cairan intravaskular menurun, ginjal akan,
bereaksi dengan melakukan reabsorpsi air dan garam,
‘melalui mekenisme neurohormonal. Sindrom hepatorenal
terjadi bila volume cairan intravaskular sangat menurun,
‘Teor ini tidak sesuai dengan hasil penelitian selanjutnya
yang menunjukkan bahwa pada pesien sirosis hati
terjadi vasodilatasi perifer, vasodilatasi splanchnic
peningkatan volume cairan intravaskuler dan cu
Jantung. Teori overfilling mengatakan bahwa asites di
dari ekspansi cairan plasma akibat reabsorpsi air
ginjal. Gangguan fungsi itu terjadi akibat peningk
aktifitas hormon anti-diuretik (ADH) dan penuru
aktifitas hormon natriuretik Karena penurunan fu
hati. Teori overfillina tidak dapat menerangkan kelanjute=
asites menjadi sindrom hepatorenal. Teori ini juga gaos
menerangkan gangguan neurohormonal yang terjes
pada sirosis hati dan asites. Evolusi dari kedua teori i
adalah teori vasocilatasi perifer. Menurut teori ini, faktor
patogenesis pembentukan asites yang amat penting
‘adalah hipertensi porta yang sering disebut sebagai faktor
lokal dan gangguan fungsi ginjal yang sering disebur,
faktor sistemik :
Akibat vasokonstriksi dan fibrotisasi sinusoid terjed
eningkatan resistensi sistem porta dan terjadi hipertens:
porta. Peningkatan resistensi vena porta diimbans:
dengan vasodilatasi splanchnic bed oleh vasodilator
endogen. Peningkatan resistensi sistem portayans
diikuti oleh peningkatan aliran darah akibat vasodilatas
splanchnic bed menyebabkan hipertensi porta menjagt
menetap. Hipertensi porta akan meningkatkan tekanan
transudlasi terutama di sinusoid dan selanjutnya kapile=
Usus. Transudat akan terkumpul di rongga peritoneum
Vasodilator endogen yang dicurigai berperan antare,
lain: glukagon, nitric oxide (NO), calcitonine gene related
peptide (CGRP), endotelin, faktor natriuretik atrial
(ANF), polipeptida vasoaktif intestinal (VIP), substans
P, prostaglandin, enkefalin, dan tumor necrosis factor
(NF).
Vasodilator endogen pada saatnya akan memengaruh
sirkulasi arterial sistemik; terdapat peningkatan vasodilatast
périfer sehingga terjadi proses underfling relatit.Tubub
‘akan bereaksi dengan meningkatkan aktifitas sistem
1984.
1985
sinin vasopresin, Akibat selanjutnya adalah peningkatan
orpsi air dan garam oleh ginjal dan peningkatan
seeks jantung
Sirosi Hati |
Hipertensi porta
Vasodiatasiarterolae splangnikus
ee
“alanan intrakapiler dan] [Volume efaktif darah |
Beier sired engat enum |
Aeteentemimese cae
| Pembentukan cairan limfe ‘Aikvasl ADA, sistem
| ebih besar daripada aliran simpatis, RAAS
J
([Terbentuk asites « —|
jetensi air dan gaer |
bergerak ke arah kaudal mendekati simpisis os
sis. Sering dijumpai hernia umbilikalis akibat tekanan
eabdomen yang meningkat. Pada perkusi, pekak
jing meningkat dan terjadi shiffting dullness. Asites
g masih sedikit belum menunjukkan tanda-tanda
= yang nyata. Diperlukan cara pemeriksaan khusus
zinya dengan pudle sign untuk menemukan asites
iksaan penunjang yang dapat memberikan informasi
sak mendeteksi asites adalah ultrasonografi, Untuk
akkan diagnosis asites, ultrasonografi mempunyai
=siltian yang tinggi.
Parasentesis diagnostik sebeiknya dilakukan pada
1p pasion asites baru. Pemeriksaan cairan asites
memberikan informasi yang amet penting untuk
eagelolaan selanjutnya, misalnya: 1). Gambaran
ekroskopik. Cairan asites hemoragik, sering dihubungkan
jan keganasan, Warna kemerahan dapat juga
pai pada asites kerena sirosis hati akibat ruptur
+ peritoneum. Chillous ascites merupakan tanda
tur pembulubh limfe, sehingga cairan limfe tumpah ke
eneum; 2). Gradien nilai albumin serum dan asites
=um-ascites albumine gradient). Pemeriksaan ini sangat,
penting untuk membedekan asites yang ada hubungannya
dengan hipertensi porta atau asites eksudet. Disepakati
bahwa gradien dikatakan tinggi bila nilainya > 1,1 gram/dlL
Kurang deri nilai itu disebut rendah. Gradien tinggi terdapat
pada asites transudasi dan berhubungan dengan hipertensi
porta sedangkan nilai gradien rendah lebih sering terdapat
pada asites eksudat. (Tebel 1) Konsentrasi protein asites,
kadang-kadang dapat menunjukkan asal asites, misalnya:
protein asites <3 gram/dl lebih sering terdapat pada asites
transudat sedangkan konsentrasi protein >3 gram/dl
sering dihubungkan dengan asites eksudat. Pemeriksaan
ini terbukti tidak akurat karena nilai akurasinya hanya
kira-kira 40%; 3). Hitung sel. Peningkatan jumlah sel lekosit
menunjukkan proses inflamasi. Untuk menilai asal infeksi
lebih tepat digunakan hitung jenis sel. Sel PMN yang
meningkat lebih dari 250/mm3 menunjukkan peritonitis
bakteri spontan, sedangkan peningkatan MN lebin sering
terjadi pada peritonitis tuberkulosa atau karsinomatosis;
4). Biakan kuman. Biakan kuman sebeiknya dilakuken
pada setiap pasien asites yang dicurigai terinfeksi. Asites
yang terinfeksi akibat perforasi usus akan menghasilkan
kuman polimikroba sedangkan peritonitis bakteri spontan
monomikroba. Metoda pengambilan sampel untuk biaken
kuman asites sebaiknya disamakan dengan sampel untuk
biokan kuman dari darah yakni bed side innoculation blood
culture botle; 5). Pemeriksaan sitologi. Pada kasus-kesus
karsinomatosis peritoneum, pemeriksaan sitologi asites
dengan cara yang baik memberikan hasil true positive
hampir 100%. Sampel untuk pemeriksaan sitologi harus
cukup banyak (kira-kira 200ml) untuk meningkatkan
sensitivitas. Harus diingat banyak tumor penghasil asites
tidak melalui mekanisme karsinomatosis peritoneum
sehingga tidak dapat dipastikan melalui pemeriksaan
sitologi asites. Tumor-tumor itu misalnya: karsinoma
hepatoselular masif, tumor hati metastasis, limtoma yang
menekan aliran limfe
Tabel 1. Klasifikas! sites Dihubungkan dengan Gradien
Albumin Serum-Asites.
Gradien tinggi Gradien rendah
Sirosis hati Karsinomatosis peritoneum
Gagal hati okut Peritonitis Tuberkulosa
Metastasis hati masif sites surgikal
Gagal jantung kongest Asics biliris
Sindrom Budd-Chiari _Penyakitjringan kat
Penyakit veno-oklusif _Sindrom nefrotik
Miksederna Asites pankreatik
PENGOBATAN
Pengobatan asites transudat sebaiknya dilakukan secara
komprehensif, meliputi:
1986
HEPATOLOS
Tirah baring. Tirah baring dapat memperbaiki efektifitas
diuretika, pada pasien asites transudat yang berhubungan
dengan hipertensi porta. Perbaikan efek diuretika
tersebut berhubungan dengan perbaikan aliran darah
ginjal dan filtrasi glomerulus akibat tirah baring. Tirah
baring akan menyebabkan aktifitas simpatis dan sistem
renin-angiotensin-aldosteron menurun. Yang dimaksud
dengan tirah baring disini bukan istirahat total di tempat
tidur sepanjang hari tetapi tidur terlentang, kaki sedikit
diangkat, selama beberapa jam setelh minum obat
diuretika.
Diet. Diet rendah garam ringan sampai sedang dapat
membantu diuresis. Konsumsi garam (NaCl) perhari
sebaiknya dibatasi hingga 40-60 meq/heri. Hiponatremia
ringan sampai sedang bukan merupakan kontraindikasi
untuk memberikan diet rendah garam, mengingat
hiponatremia pada pasien asites transudat bersifat relat.
Jumlah total Na dalam tubuh sebenarnya di atas normal
Biasanya diet rendah garam yang mengandung NaCl
kurang dari 40 mEq/hari tidak diperlukan. Konsentrasi
NaCl yang amat rendah justru dapat mengganggu fun:
* ginjal
Diuretika. Diuretika yang dianjurkan adalah diuretika yang
bekeija sebayei antialdusterun, tnisaliya spirunolakion,
Diuretika ini merupakan diuretika hemat kalium, bekerja
di tubulus distal dan menahan reabsorpsi Na. Sebenarnya
potensi natriuretik diuretika distal lebih rendah dari
pada diuretika loop bila etiologi peningkatan air dan
garam tidek berhubungan dengan hiperaldosteronisme.
Efektfitas obat ini lebih bergantung pada konsentrasinya
di plasma, semakin tinggi semakin efektif. Dosis yang
dianjurkan antara 100 - 600mg/har. Jarang diperlukan
dosis yang lebih tinggi lagi.
Diuretika loop sering dibutuhkan sebagai kombinasi.
Diuretika ini sebenarnya lebih berpotensi daripada
diuretika distal. Pada sirosis hati, karena mekanisme utama
reabsorpsi air dan natrium adalah hiperaldosteronisme,
diuretika loop menjadi kurang efektit.
Target yang sebaiknya dicapai dengan terapi tirah
baring, diet rendah garam dan terapi diuretika adalah
peningkatan diuresis sehingga berat badan turun 400-800
hari, Pasien yang disertai edema perifer penurunan berat
badan dapat sampai 1500 g/hari, Sebagian besar pasien
berhasil beik dengan terapi kombinasi tirah baring, diet
rendah garam dan diuretika kombinasi. Setelah cairan
asites dapat dimobilisasi, dosis diuretika dapat disesuaikan,
Biasanya diet rendah garam dan spironolakton masih tetap
Anda mungkin juga menyukai
- Panduan Pemeriksaan Oftalmologi KoasBelum ada peringkatPanduan Pemeriksaan Oftalmologi Koas111 halaman
- Teknik Perkusi Thorax untuk DiagnosisBelum ada peringkatTeknik Perkusi Thorax untuk Diagnosis1 halaman
- Ikterus Obstruktif Et Causa Koledokolitiasis Disertai Kolangitis Dan Kolesistitis60% (5)Ikterus Obstruktif Et Causa Koledokolitiasis Disertai Kolangitis Dan Kolesistitis92 halaman
- Radiologi dan Diagnosis CDH pada BayiBelum ada peringkatRadiologi dan Diagnosis CDH pada Bayi32 halaman
- Embriologi Inguinal Canal Dan Penurunan TestisBelum ada peringkatEmbriologi Inguinal Canal Dan Penurunan Testis6 halaman
- Diagnosa dan Pengobatan TB AbdominalisBelum ada peringkatDiagnosa dan Pengobatan TB Abdominalis29 halaman
- Gambaran Radiologi Epidural HematomaBelum ada peringkatGambaran Radiologi Epidural Hematoma29 halaman
- Glomerulonefritis Akut Pascastreptokokus (GNAPS)Belum ada peringkatGlomerulonefritis Akut Pascastreptokokus (GNAPS)15 halaman
- CASE REPORT Diagnosis Dan Tata Laksana Kolesistitis Akalkulus AkutBelum ada peringkatCASE REPORT Diagnosis Dan Tata Laksana Kolesistitis Akalkulus Akut8 halaman
- Nyeri Perut Akut: Diagnosis KolesistitisBelum ada peringkatNyeri Perut Akut: Diagnosis Kolesistitis9 halaman
- Penanganan Darurat Anestesi dan KecelakaanBelum ada peringkatPenanganan Darurat Anestesi dan Kecelakaan6 halaman
- Diare Berdarah: Penyebab dan PenangananBelum ada peringkatDiare Berdarah: Penyebab dan Penanganan40 halaman
- Keluhan Nyeri Perut Bagian Bawah, Serta Keluar Sekret Kuning Kental Dan Bau Dari Jalan Lahir Tes Kehamilan ( ) Chandelier Sign (+)Belum ada peringkatKeluhan Nyeri Perut Bagian Bawah, Serta Keluar Sekret Kuning Kental Dan Bau Dari Jalan Lahir Tes Kehamilan ( ) Chandelier Sign (+)3 halaman
- Trauma Tumpul Ginjal: Diagnosis dan PenangananBelum ada peringkatTrauma Tumpul Ginjal: Diagnosis dan Penanganan72 halaman
- Penyebab dan Penanganan Asites pada Kanker OvariumBelum ada peringkatPenyebab dan Penanganan Asites pada Kanker Ovarium3 halaman
- Asites: Penyebab, Gejala, dan PenangananBelum ada peringkatAsites: Penyebab, Gejala, dan Penanganan7 halaman
- Asites: Definisi, Penyebab, dan PenangananBelum ada peringkatAsites: Definisi, Penyebab, dan Penanganan14 halaman